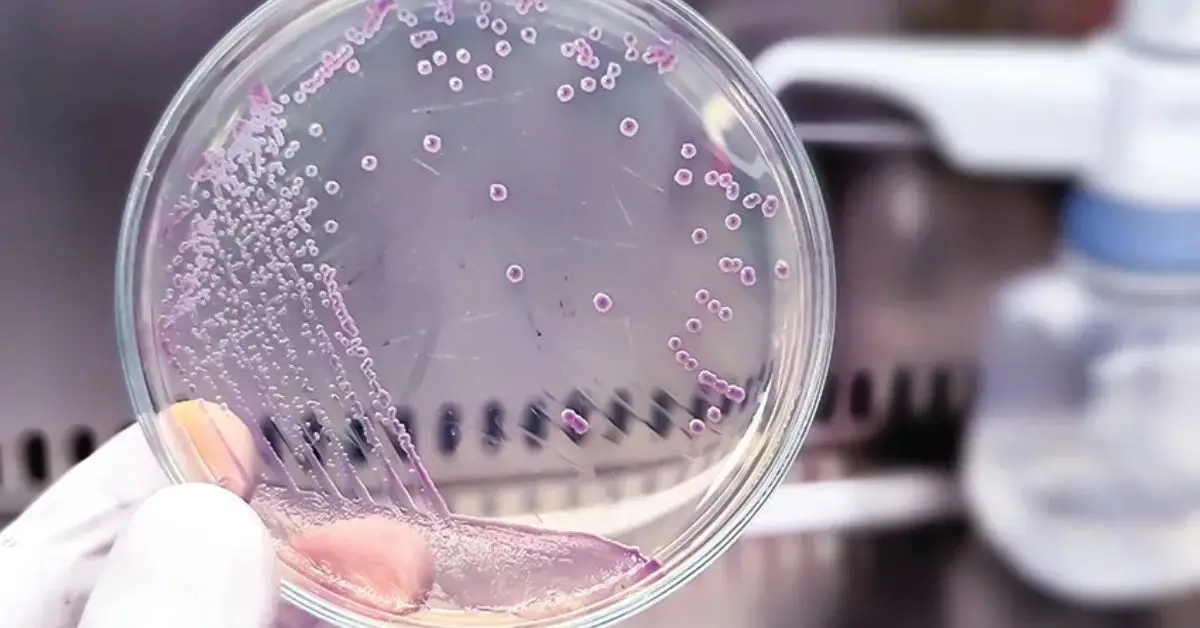
Kitchen Cleaning Mistakes

Microbiologists Warn: 12 Kitchen Cleaning Mistakes You’re Still Making
I’ll be honest—I used to think my kitchen was clean just because it looked clean. Counters wiped, dishes done, trash out. Then I started reading what microbiologists actually say about everyday kitchen habits, and it was uncomfortable. Some of the most common kitchen cleaning mistakes are the exact things we’ve been doing for years without questioning them.
In this article, I’m not repeating the usual advice. I’m breaking down kitchen cleaning mistakes that microbiologists genuinely warn against—based on how germs spread, survive, and move from one surface to another. This isn’t about fear. It’s about understanding what’s really happening in your sink, sponge, fridge, and hands so you can stop problems before they start.
If you’ve ever thought, “I’ve been cleaning my kitchen this way forever—can it really be that bad?” keep reading. Which one of these mistakes do you think you might be making right now?
Getting the Basics Wrong — Core Kitchen Cleaning Mistakes
This is where I see most people—smart, careful people—go wrong. Not because they’re lazy, but because they trust habits that feel clean. You and I were taught certain kitchen rules growing up, and no one ever updated them based on how bacteria actually behave.
Let’s fix that, starting with the basics.
Mistake #1 — Using the Wrong Water Temperature

I used to believe that very hot water alone could “kill everything.” That belief is common—and wrong.
Here’s what microbiologists point out (and what sources like SELF explain clearly): Water temperature by itself does not disinfect. Soap does the heavy lifting by breaking down grease and bacterial membranes. Temperature just supports the process.
What actually works:
- Warm water helps soap work better, especially on grease
- Extremely hot water without soap doesn’t remove bacteria effectively
- Cold water + soap still cleans, but needs more friction and time
Why this matters microbiologically:
- Bacteria stick to grease and food residue
- Soap lifts that residue so bacteria can be rinsed away
- Heat alone doesn’t remove what bacteria are clinging to
If you’ve been relying on heat instead of proper washing, you’re not alone—but this small shift can instantly improve how safe your dishes really are.
Mistake #2 — Washing Dishes in a Dirty Sink
This one surprises almost everyone I talk to.
Your sink looks clean, but it’s often one of the most contaminated spots in the entire kitchen. Raw food juices, leftover particles, and moisture collect there all day.
The mistake I see:
- You rinse the sink quickly
- Then wash dishes in it
- Assuming “running water” makes it clean
The key thing most people miss is the difference between:
- Cleaning → removing visible dirt
- Disinfecting → reducing bacteria on the surface
Why this causes cross-contamination:
- Dirty sinks transfer bacteria back onto clean dishes
- Moist environments help bacteria survive longer
- You undo good dishwashing habits without realizing it
A quick sink clean before dishwashing makes a bigger difference than scrubbing plates harder.
Mistake #3 — Ignoring Hygiene When You Have Cuts or Wounds

I’ve done this myself—tiny cut, no big deal, dishes still need to be washed. But microbiologists warn against this for a reason.
Open cuts are an easy entry point for bacteria commonly found in kitchens, including Staphylococcus.
What puts you at risk:
- Washing dishes with uncovered cuts
- Prolonged exposure to dirty water
- Scrubbing motions that reopen small wounds
Simple habits that protect you:
- Use waterproof gloves when you have cuts
- Cover wounds with proper bandages
- Avoid soaking hands in dishwater
This isn’t about being dramatic. It’s about preventing infections that start quietly and become a problem later.
Tools & Habits That Spread Bacteria Instead of Removing It
This is where cleaning routines quietly betray you. I’ve seen it happen again and again—you’re putting in effort, but certain tools and habits are actually helping bacteria survive longer and travel farther. Most people never question these steps because they feel productive.
Let’s break that illusion.
Mistake #4 — Letting Surfaces Stay Moist After Cleaning
After cleaning, many people just walk away. I used to do the same. The problem is moisture doesn’t mean “fresh”—it means bacteria-friendly.
From a microbiology point of view:
- Damp surfaces allow bacteria to multiply faster
- Moisture extends bacterial survival time
- “Air drying eventually” still gives germs a head start
What works better:
- Wipe sinks dry after washing dishes
- Stand cutting boards upright to dry completely
- Don’t stack wet utensils on top of each other
Drying isn’t optional—it’s the final hygiene step that actually stops growth.
Mistake #5 — Over-Scrubbing Instead of Soaking

Hard scrubbing feels satisfying, but it’s not always smart. Aggressive scrubbing can spread bacteria across surfaces and even create tiny scratches where germs hide.
Cleaning experts often point out—like those quoted in Tasting Table’s breakdown of common kitchen cleaning mistakes—that soaking lets soap loosen grease and food residue first, so bacteria release instead of spreading.
Why soaking wins:
- Less force, less spread
- Soap gets time to break down residue
- Surfaces stay smoother and easier to clean
Scrubbing harder doesn’t mean cleaning better.
Mistake #6 — Never Replacing Sponges
If I had to name one tool that causes the most damage, it’s the sponge.
Sponges trap food, stay damp, and get reused for days. That combination makes them a perfect place for bacteria to explode in numbers—even if they don’t smell.
Common mistakes:
- Keeping the same sponge for weeks
- Thinking rinsing makes it safe
- Waiting for a bad odor as a warning sign
Smarter habits:
- Replace sponges every 1–2 weeks
- Let them dry fully between uses
- Rotate sponges instead of stretching one too long
Sometimes the cleanest move is throwing it out. Many people either overuse sponges or throw away useful kitchen items without realizing their value—if you’re trying to clean smarter, not waste more, this guide on kitchen items you should never throw away even if you’re decluttering can help you strike that balance.
Mistake #7 — Using One Sponge for Everything

This is pure cross-contamination, and almost everyone does it.
When one sponge touches:
- The sink
- Countertops
- Raw food messes
- Dishware
You’re moving bacteria from one zone to another without realizing it.
A simple fix:
- One sponge for dishes only
- One cloth for counters
- Separate tool for raw meat areas
Cleaning tools don’t just remove germs—they carry them. Once you understand that, your kitchen hygiene improves fast.
Surfaces & Storage — Where Germs Actually Live
You and I usually clean what looks dirty. But germs don’t live by appearance—they live by contact, moisture, and food residue. Once I started looking at kitchens from a microbiology lens, it became obvious why some “clean” kitchens still cause problems.
What’s interesting is that many of these overlooked areas are also the same details visitors subconsciously notice—this breakdown of things guests instantly notice in your kitchen that you don’t explains why these spots matter more than people realize.
Mistake #8 — Neglecting Fridge Cleanup After Moldy Food

Most people remove the moldy item and close the fridge. I used to do the same. The issue is that mold and spoiled food don’t stay limited to one container—they release spores and bacteria that spread inside the fridge.
What actually happens:
- Mold spores move through fridge airflow
- Bacteria settle on shelves and drawers
- Nearby food gets exposed without visible signs
Proper cleanup means:
- Removing all food from the affected area
- Washing shelves and drawers with soap and warm water
- Drying everything completely before putting food back
This matters because, as explained in the Microbiology Society’s overview of how microbes behave, bacteria spread based on environment—not visibility.
Mistake #9 — Focusing Only on Counters But Ignoring Touch-Points
Counters get cleaned because they look dirty. Touch-points don’t—and that’s why they’re risky.
Think about how often you touch:
- Fridge handles
- Cabinet knobs
- Drawer pulls
- Light switches
Now think about how rarely you clean them.
Why this causes problems:
- Hands move bacteria constantly
- Touch-points transfer germs to clean surfaces
- You re-contaminate food areas without realizing it
Better habit:
- Wipe touch-points daily
- Clean them before cooking
- Treat them like high-risk surfaces
These spots don’t look dangerous—but they are.
Mistake #10 — Forgetting to Clean the Dishwasher

Most people assume dishwashers clean themselves. They don’t.
What builds up over time:
- Food particles in filters
- Grease on interior walls
- Moisture trapped between cycles
What that leads to:
- Odors
- Poor cleaning results
- Bacterial buildup
What actually works:
- Rinse the filter regularly
- Run an empty hot cycle with vinegar monthly
- Leave the door open after use so it dries
A dirty dishwasher can’t clean properly. The same buildup issue happens in other appliances too—and this step-by-step guide on deep cleaning a washing machine using only kitchen ingredients shows how to handle it without harsh chemicals.
Mistake #11 — Cross-Contaminating With Cutting Boards
Cutting boards may look solid, but they’re full of tiny grooves. When the same board is used for raw meat and produce, bacteria get trapped and transferred.
Why this matters:
- Micro-cracks hold bacteria
- Rinsing doesn’t remove embedded germs
- Produce gets contaminated after washing
Smarter approach:
- Separate boards for meat and produce
- Use non-porous boards when possible
- Clean, sanitize, and dry properly
This is food safety—not just surface cleaning.
Mistake #12 — Treating the Trash Can as “Just Trash”
Trash cans stay damp, trap food residue, and get touched often. That makes them a perfect breeding ground for bacteria.
Common oversights:
- Ignoring the bottom of the bin
- Not cleaning lids or pedals
- Replacing bags without washing the can
Better routine:
- Wash the trash can regularly
- Dry it fully before adding a new liner
- Clean lids and pedals too
Trash doesn’t stay in the trash can—germs travel.
Microbiology Reality Checks — What Most Cleaning Advice Gets Wrong
This is where I want you to pause for a second. Most kitchen advice online skips the science part. It tells you what feels clean, not what actually reduces bacteria. Microbiology fills that gap.
Why Temperature, Moisture & Contact Time Matter
Bacteria don’t die just because something looks clean. They respond to conditions.
From a microbiology standpoint:
- Moisture helps bacteria survive and multiply
- Warmth speeds up bacterial growth
- Contact time decides whether cleaning works or fails
If soap doesn’t stay on a surface long enough, bacteria don’t fully detach. If moisture stays behind, they grow back faster.
What this means for you:
- Quick wipe-downs aren’t enough
- Drying matters as much as washing
- Rushing the process cancels out your effort
Cleaning isn’t about force. It’s about conditions.
Myth vs Microbiology — The Five-Second Rule Isn’t Real
I grew up hearing it. You probably did too. Drop food, pick it up fast, it’s safe. That rule feels comforting—and it’s wrong.
Microbiology research shows that bacteria can transfer immediately on contact. There’s no safe countdown. The moment food touches a contaminated surface, microbes can move.
The scientific consensus—summarized well in simple:
- Contact happens instantly
- Surface cleanliness matters more than time
- “Fast pickup” doesn’t prevent contamination
If food hits the kitchen floor or counter, the decision isn’t about seconds—it’s about risk.
A Simple Kitchen Hygiene Checklist
I like systems because they remove guesswork. Here’s a realistic hygiene checklist you can actually stick to.
Daily
- Wipe counters, sink, and touch-points
- Dry sinks and boards after use
- Replace damp cloths
Weekly
- Clean fridge shelves and drawers
- Wash sponges or replace if worn
- Clean dishwasher filter
Monthly
- Deep clean trash can
- Run dishwasher cleaning cycle
- Check cutting boards for wear
Tools to use
- Separate cloths for dishes and counters
- Soap + warm water
- Gloves when needed
Things to avoid
- Mixing cleaning chemicals
- Using one sponge everywhere
- Overusing bleach without rinsing
Simple habits beat aggressive cleaning every time.
Final Note on Safety & Cleaning Toxicity
One last thing I don’t want you to ignore.
More chemicals don’t mean more safety. In fact, mixing cleaners—especially bleach with ammonia—creates toxic fumes that are genuinely dangerous.
Always:
- Ventilate the kitchen while cleaning
- Follow product instructions
- Rinse surfaces that touch food
A healthy kitchen shouldn’t make you sick while you’re cleaning it.
Be honest—which habit from this article are you going to change first? Drop it in the comments so others can learn from it too.
And if you want more practical, no-nonsense guides like this, check out Build Like New—that’s where I break down everyday home habits so you can fix what actually matters.
Disclaimer: This content is for general informational purposes only. It does not replace professional medical or health advice. Always follow product instructions and consult a qualified professional if you have health concerns related to cleaning chemicals or hygiene.


